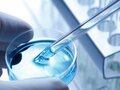
Đáp án câu hỏi thảo luận trang 94 sgk sinh học 9

Đáp án bài 3 trang 95 sgk sinh học 9
Xem cách làm và đáp án bài 3 trang 95 SGK sinh học lớp 9 để hiểu hơn về công nghệ sinh học là gì và gồm những lĩnh vực nào...
Soạn sinh học 9 bài 32 công nghệ gen giúp bạn ôn tập kiến thức và trả lời tốt các câu hỏi bài tập trang 95 SGK Sinh học 9.

Tài liệu hướng dẫn soạn sinh 9 bài 32 được ĐọcTàiLiệu biên soạn không chỉ giúp bạn trả lời tốt các câu hỏi trang 95 sách giáo khoa, mà còn nắm vững các kiến thức quan trọng của bài học về công nghệ gen đã được học.
Cùng tham khảo...
Các nội dung quan trọng của bài học bạn cần ghi nhớ:
1. Kĩ thuật gen là tập hợp những phương pháp tác động định hướng lên ADN cho phép chuyển thông tin di truyền từ một cá thể của một loài sang cá thể của loài khác.
2. Kĩ thuật gen gồm ba bước ứng với ba phương pháp cơ bản là" tách, cắt nối để tạp ADN tái tổ hợp rồi đưa và tế bào nhận.
3. Trong sản xuất, kĩ thuật gen được ứng dụng trong việc tạo ra các sản phẩm sinh học, tạo ra các giống cây trồng và động vật biến đổi gen.
4. Công nghệ sinh học là một ngành công nghệ sử dụng tế bào sống và các quá trình sinh học để tạo ra các sản phẩm sinh học cần thiết cho con người. Công nghệ sinh học gồm các lĩnh vực là: Công nghệ lên men, công nghệ tế bào, công nghệ enzim, công nghệ chuyển nhân và chuyển phôi, công nghệ sinh học xử lí môi trường, công nghệ gen, công nghệ sinh học y dược.

Xem cách làm và đáp án bài 3 trang 95 SGK sinh học lớp 9 để hiểu hơn về công nghệ sinh học là gì và gồm những lĩnh vực nào...

Xem ngay hướng dẫn cách làm và đáp án bài 2 trang 95 sách giáo khoa sinh học lớp 9

Hướng dẫn giải bài tập và đáp án bài 1 trang 95 SGK sinh học lớp 9
Câu trả lời cho công nghệ là gì sẽ có trong câu hỏi thảo luận trang 94 sgk sinh học lớp 9

Công nghệ gen là gì? kỹ thuật gen gồm những khâu chủ yếu nào...., chúng ta đều có câu trả lời trong câu hỏi thảo luận trang 93 sgk sinh học 9